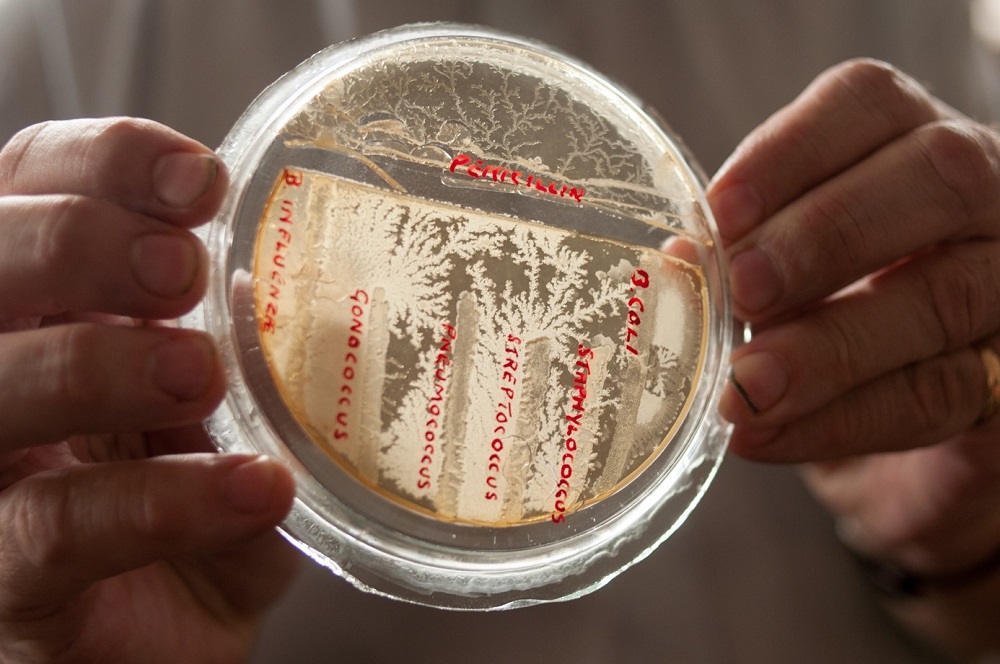
fingre, plate med bakterier

De siste årene har vi sett en økning i antall gonoréinfeksjoner som ikke lar seg behandle med vanlige antibiotika, særlig blant unge i Norge. I denne panelsamtalen utforsker vi dette temaet, med fokus på hva vi som enkeltmennesker og som samfunn kan gjøre for å stoppe utviklingen av resistent gonoré.
Velkommen enkel servering og panelsamtale på Scene HumSam!
Du møter:
- Anne Olaug Olsen, lege og spesialist i hud- og veneriske sykdommer og i samfunnsmedisin, overlege ved Avdeling for smittevern og vaksine på Folkehelseinstituttet og førsteamanuensis ved Avdeling for samfunnsmedisin og global helse på Universitetet i Oslo.
- Sigurd Høye, allmennlege, leder for Antibiotikasenteret for primærmedisin og førsteamanuensis på Avdeling for samfunnsmedisin ved Universitetet i Oslo.
- Oda Melina S. Joramo, som nylig har skrevet masteroppgave om smittesporing av gonoré ved Avdeling for helseledelse og helseøkonomi.
- Samtaleleder: Amanda Hylland Spjeldnæs, medisinstudent på forskerlinja på Institutt for helse og samfunn.
Ingen påmelding
Arrangementet er åpent for alle og krever ikke påmelding.
Scene HumSam
Scene HumSam ligger i første etasje i HumSam-biblioteket i Georg Sverdrups hus.
Antibiotikauka 2023
Dette arrangementet er en del av Antibiotikauka 2023 på Universitetet i Oslo, som er en del av Verdens Helseorganisasjons World Antimicrobial Awareness Week. (WAAW).